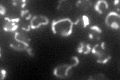
YLR203C
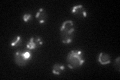
YLR203C

View description
Specific translational activator for the mitochondrial COX1 mRNA; loosely associated with the matrix face of the mitochondrial inner membrane; influences both COX1 mRNA translation and Cox1p assembly into cytochrome c oxidase
Localization:
Intensity:
Fold change:
Significance:
-
C’ GFP library in SD
mitochondria74.68 -
N' NOP1pr-GFP in SD

mitochondria97.3948 -
N' TEF2pr-mCherry in SD

missing0 -
N' NATIVEpr-GFP in SD

mitochondria25.1417 -
N' TEF2pr-VC and Cyto-VN in SD

#N/A0 -
C’ GFP library in SD+DTT

mitochondria91.721.22No -
C’ GFP library in SD+H2O2

vacuole membrane70.020.93No -
C’ GFP library in Starvation Media
mitochondria64.220.85No -
C’ GFP library on the background of Pup2-DaMP

mitochondria -
C’ GFP library on the background of CCT mutant

mitochondria86.53871.15862No
